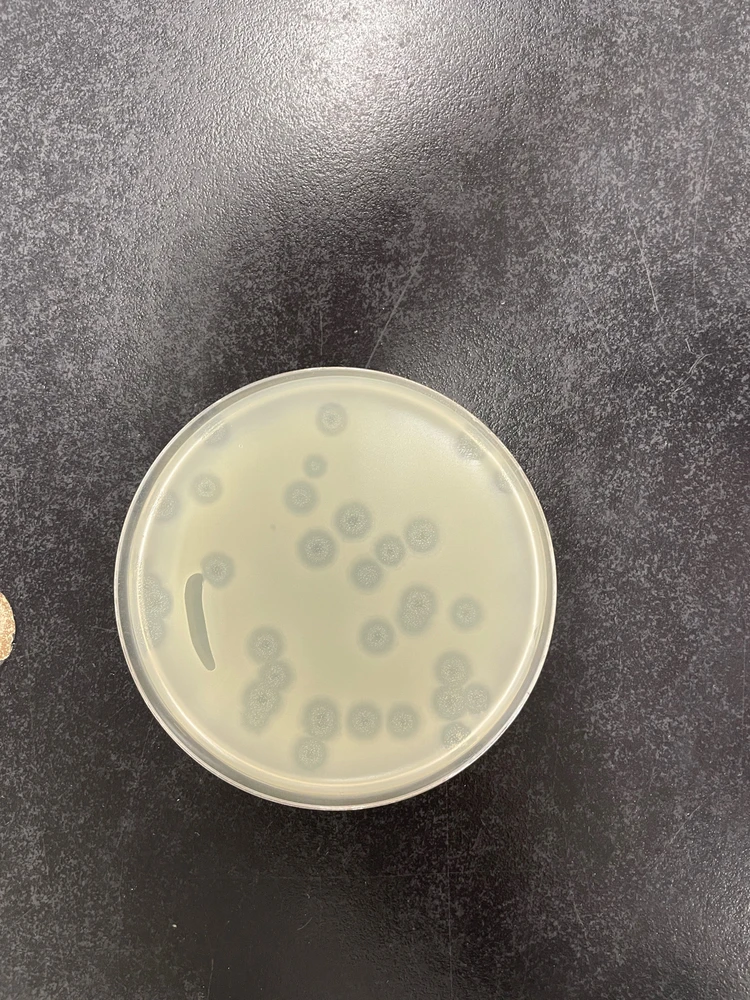
GIF uploaded by Genesis

4.2M souls
7.6K souls
1.8K souls
118K souls
76K souls
56K souls
55K souls
37K souls
30K souls
26K souls
25K souls
17K souls
12K souls
12K souls
6.7K souls
6.2K souls
5.5K souls
5.4K souls
3.7K souls
3K souls
2.8K souls
2.6K souls
2.6K souls
2.3K souls
2.3K souls
2.2K souls
2K souls
1.8K souls
1.5K souls
799 souls
779 souls
716 souls
678 souls
665 souls
585 souls
541 souls
502 souls
487 souls
486 souls
484 souls
451 souls
390 souls
369 souls
343 souls
302 souls
289 souls
281 souls
275 souls
273 souls
269 souls
264 souls
262 souls
261 souls
254 souls
248 souls
244 souls
243 souls
227 souls
226 souls
220 souls
208 souls
200 souls
196 souls
181 souls
181 souls
179 souls
175 souls
171 souls
171 souls
169 souls
164 souls
164 souls
161 souls
142 souls
141 souls
141 souls
135 souls
129 souls
124 souls
120 souls
120 souls
119 souls
118 souls
115 souls
110 souls
108 souls
100 souls
100 souls
100 souls
98 souls
96 souls
96 souls
95 souls
93 souls
91 souls
88 souls
82 souls
82 souls
79 souls
79 souls
76 souls
76 souls
74 souls
70 souls
68 souls
68 souls
65 souls
65 souls
60 souls
60 souls
60 souls
59 souls
58 souls
58 souls
58 souls
57 souls
57 souls
56 souls
55 souls
52 souls
49 souls
48 souls
48 souls
45 souls
45 souls
45 souls
44 souls
43 souls
42 souls
41 souls
41 souls
41 souls
40 souls
40 souls
39 souls
39 souls
39 souls
38 souls
38 souls
38 souls
38 souls
37 souls
35 souls
34 souls
34 souls
33 souls
33 souls
33 souls
31 souls
31 souls
31 souls
30 souls
30 souls
30 souls
30 souls
30 souls
29 souls
29 souls
29 souls
27 souls
26 souls
26 souls
25 souls
25 souls
25 souls
25 souls
24 souls
24 souls
24 souls
23 souls
22 souls
22 souls
22 souls
21 souls
21 souls
21 souls
20 souls
20 souls
20 souls
19 souls
19 souls
19 souls
19 souls
18 souls
18 souls
18 souls
17 souls
17 souls
17 souls
17 souls
17 souls
17 souls
16 souls
16 souls
16 souls
16 souls
15 souls
15 souls
15 souls
15 souls
14 souls
13 souls
13 souls
13 souls
13 souls
13 souls
12 souls
12 souls
12 souls
12 souls
11 souls
11 souls
11 souls
11 souls
11 souls
10 souls
10 souls
10 souls
10 souls
9 souls
9 souls
9 souls
9 souls
9 souls
9 souls
8 souls
8 souls
8 souls
7 souls
7 souls
7 souls
7 souls
7 souls
6 souls
6 souls
6 souls
6 souls
6 souls
6 souls
5 souls
5 souls
5 souls
5 souls
5 souls
5 souls
5 souls
5 souls
5 souls
4 souls
4 souls
4 souls
4 souls
4 souls
4 souls
4 souls
4 souls
4 souls
4 souls
4 souls
4 souls
4 souls
4 souls
4 souls
3 souls
3 souls
3 souls
3 souls
3 souls
3 souls
3 souls
3 souls
3 souls
3 souls
3 souls
3 souls
3 souls
3 souls
3 souls
3 souls
2 souls
2 souls
2 souls
2 souls
2 souls
2 souls
2 souls
2 souls
2 souls
2 souls
2 souls
2 souls
2 souls
2 souls
2 souls
2 souls
2 souls
2 souls
2 souls
2 souls
1 souls
1 souls
1 souls
1 souls
1 souls
1 souls
1 souls
1 souls
1 souls
1 souls
1 souls
1 souls
1 souls
1 souls
1 souls
1 souls
1 souls
1 souls
1 souls
1 souls
1 souls
1 souls
0 souls
0 souls
0 souls
The stem community, chat, and discussion.
1.9K souls
1.9K souls
4mo
ESFP
Sagittarius
I've been doing more STEM based projects because of digimon. I upgraded the screen to a Wonderswan then soldered a pcb for an audio jack.









2
1
8mo
ENTJ
1
1
10mo
ENTJ


4
5
11mo
ENTJ
3
8
10mo
ENTJ
3
3
10mo
ENTJ
4
4
Meet New People
50,000,000+
DOWNLOADS
Related Posts
1d
INTJ
Virginia Woolf - A Room For One's Own In the right conditions one can dare think. Nowadays we have better conditions and we see the numbers of women in stem and arts go up because they can afford to think of atoms and cosmology and painting and writing. Nowadays women are also allowed in... read more

8
8
21d
INFJ
Taurus
3 month rule = no sex, or close intimacy or established exclusivity until we've been dating for AT LEAST 3 months (my preference is 6). This gives time to learn WHO that person is, observe their actions, behaviours, intent and see who they REALLY are before becoming exclusive and then considering... (edited) read more

7
22
23d
ENFP
Gemini
I hate chemistry with a passion and would consider transferring from Earth science (love the major hate the prerequisites) to Environmental studies if I had some confidence that I could get a job with the degree.
1
2
4mo
INFP
Sagittarius
My hobby is to play guitar and singing, I'm a stem student who wants to pursue both passion and career:3
5
2
10mo
INFP
Virgo
I saw a quote that said, ”A different version of you exists in the minds of everyone you’ve ever met.” That statement alone filled me with so much anxiety. …because I’m the type of person who wants to make sure the version eveyone has of me is good. I can overthink even the smallest interaction... read more
13
5
6mo
INFJ
Taurus
I think everyone should do one of these every once in a while to boost themselves up! Whenever I feel down or my mental health is struggling I try and do this more to ground myself and hype myself up: - I may have come from a poor background but I've managed to leave my home isles by myself at 17... read more

9
5